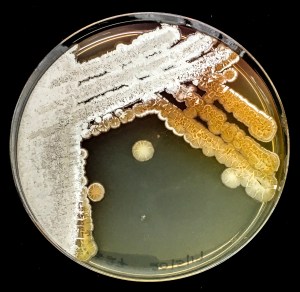
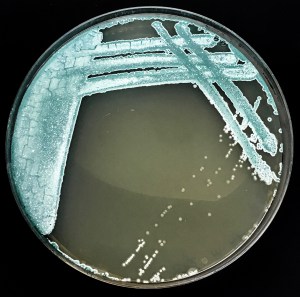

Overview
In 2022 Project Baseline UK will team up with Strathclyde University to support the Dive for Antibiotics (DFA) project. Volunteer divers will collect sediment from underwater environments for use in antibiotics research.
DFA is recruiting divers willing to collect marine sediments from their dives. These sediment samples will be analysed for potential new antibiotic compounds that could help with the current antimicrobial resistance crisis.
This year DFA is running a competition where the diver who provides the sample producing the most interesting compounds will win a Shearwater Teric computer, with lots of great runner-up prizes for other interesting samples. Divers can sign up here, or via the DFA instagram page at @diveforantibiotics.

What is the Dive for Antibiotics project?
Antimicrobial resistance, known as AMR, is a global crisis. Bacteria causing serious life-threatening infections are now resistant to many or all of our available antibiotics. This means that treatment options for these serious infections are limited or even non-existent.
To continue to treat such infections, new antibiotics are desperately needed. The vast majority of our current antibiotics are derived from compounds originating from bacteria or fungi. Soil bacteria from the group Actinobacteria (now known as Actinomycetota) provide over two-thirds of our antibiotics. Unfortunately, we are not finding new types of Actinobacteria and new antibiotics any longer, as many environments have been extensively sampled. As a result, scientists have now turned to search more extreme environments which might contain Actinobacteria we have never encountered before. The marine biosphere covers 70% of the planet, is incredibly biodiverse and mostly unexplored, meaning it likely contains a wealth of untapped Actinobacteria and antimicrobial compounds.
Random sampling of environments has been the most successful approach to antibiotic discovery so far and many of our most powerful and used antibiotics have been discovered in unexpected places by members of the public. Notably, the strain of mold which produces penicillin for industrial production was found by Mary Hunt on a moldy cantaloupe in a grocery store. Other microorganisms which produce key antibiotics were originally discovered in gardens, on golf-courses, or in unassuming mud. The bacteria Salinaspora was discovered in a marine sediment sample taken in 1989 by divers in the Bahamas, and produces a range of antimicrobial compounds or other medicinally useful drugs.
The Dive for Antibiotics (DFA) project is an initiative that relies on volunteer divers to collect sediment samples from which Actinobacteria can be isolated and screened for production of bioactive compounds capable of killing harmful microorganisms. The aim of the project is to find novel antimicrobials whilst providing education and information about antibiotic discovery, antimicrobial resistance, and microbiology in general.
As part of this, the DFA project is running a global competition offering divers a chance to sign up to collect sediment and return it to our lab for a chance to win some great prizes. We are looking for the most interesting and novel isolate we can find!

